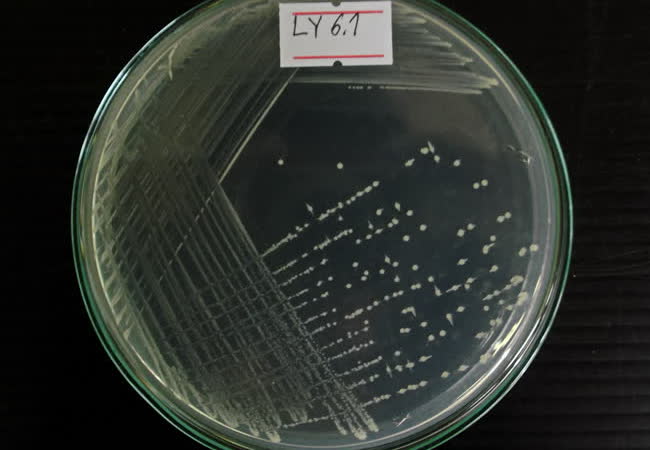

- พิชัย พงษ์อุดม
- Geosmin, 2-methylisoborneol, กลิ่นไม่พึงประสงค์, การย่อยสลายโดยจุลินทรีย์
- 22 ตุลาคม 2558
ชนกันต์ จิตมนัส
ผลงานทั้งหมด
- เชษฐา ดวงสุวรรณ์
- การจัดการเรียนรู้, การรวมกลุ่มเกษตรกร, การเลี้ยงปลานิล
- 26 พฤศจิกายน 2561
- วิญญู บุญประเสริฐ
- ปลากะพงขาววัยรุ่น, สีน้ำเทียม, กิจกรรมเอนไซม์, ทริปซิน, ไคโมทริปซิน, ระบบน้ำหมุนเวียน
- 4 สิงหาคม 2563